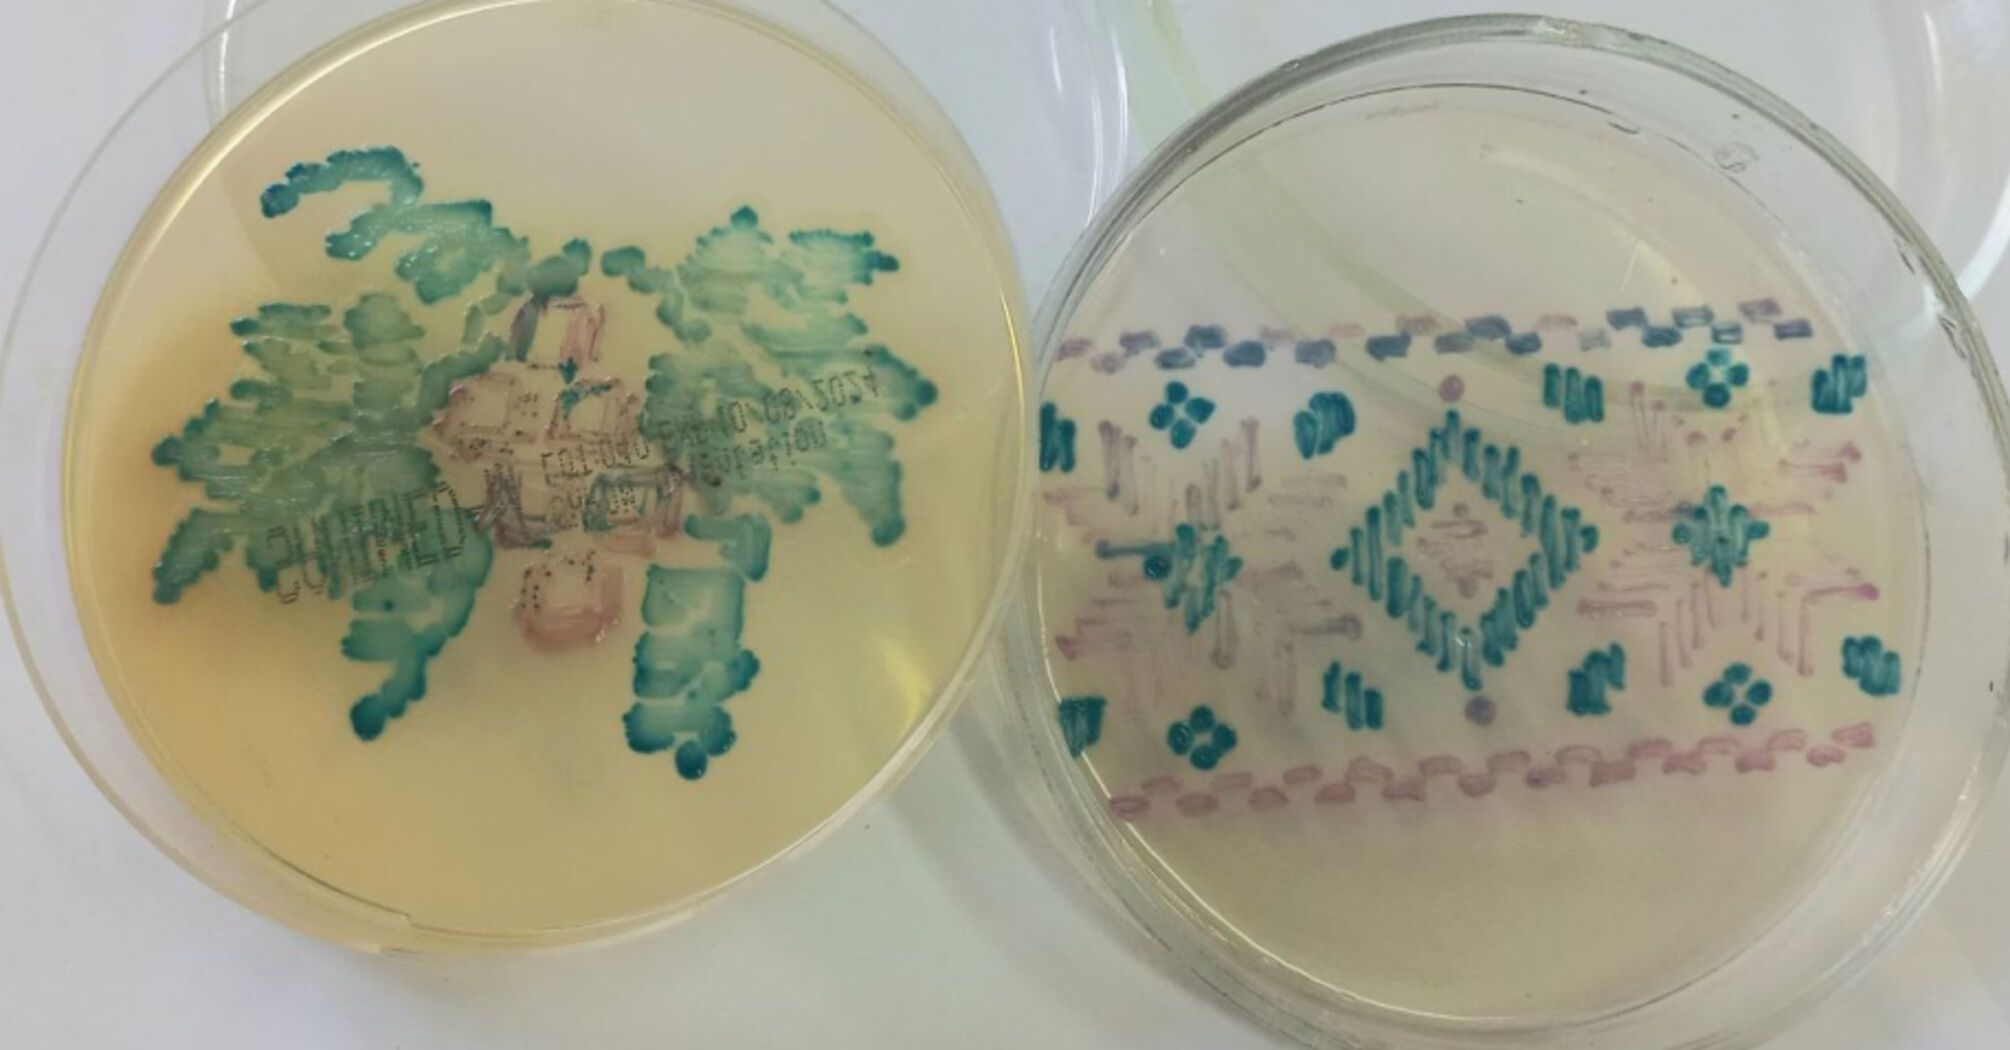

News
A Ukrainian woman created embroidery from bacteria: scientists appreciated it. Photo
Bacteriologist Ruslana Taraniuk from Volyn created an unusual embroidered shirt. The scientist used bacteria to produce colored patterns on a chromogenic medium.
The Volyn woman's work won the All-Ukrainian Microbiology Competition. The judges appreciated not only the scientific but also the creative approach to microbiology, writes Rayon Medicine.
Ruslana Taraniuk, acting head of the centralized clinical microbiology department with the cytogenetics department at the Volyn Oblast Children's Territorial Medical Association for the Protection of Motherhood and Childhood, emphasized that she loves her job and also appreciates Ukrainian traditions.
"I love bacteriology very much. I believe that a person who does not love his or her profession should not be engaged in it: results and peaks can only be achieved by being passionate about what you do. For Ukraine, embroidery is our cultural code, and this time I had an idea to make an embroidery with bacteria on a chromogenic medium for the drawing competition," the doctor explained.
According to the scientist, the chromogenic environment is often used in her work to detect dangerous bacteria, such as Streptococcus agalactiae, which causes serious illnesses in newborns. This technique helps to diagnose infections faster and prescribe treatment in a timely manner.
However, it is not easy to create patterns on a seemingly completely unsuitable background. "To do this, you need to take into account how and on what chromogenic environment, what color a particular microorganism will grow. First, you need to prepare a sketch, and then a drawing is made based on the sketch," the bacteriologist said.
Ruslana Taraniuk emphasized that the idea to use embroidery in her work was not accidental. "This is both a patriotic message and an opportunity to use the very media we use in our work for creativity. I wanted to demonstrate that even on such a highly specialized medium as group B streptococci, it is possible to make an interesting drawing," the head of the department said.
Only verified information is available on the OBOZ.UA Telegram channel and Viber. Do not fall for fakes!